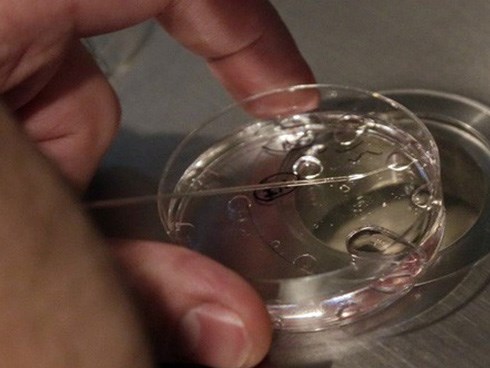

Chủ đề
sinh viên đẹp
sinh viên đẹp
Dụ dỗ sinh viên đẹp, học giỏi bán trứng với giá 14.600 USD
Theo một cuộc điều tra mới đây của Beijing Youth Daily, sinh viên nữ của một số trường đại học ở Trung Quốc bị lôi kéo bán trứng với giá lên tới 100.000 nhân dân tệ, tương đương 14.600 USD.